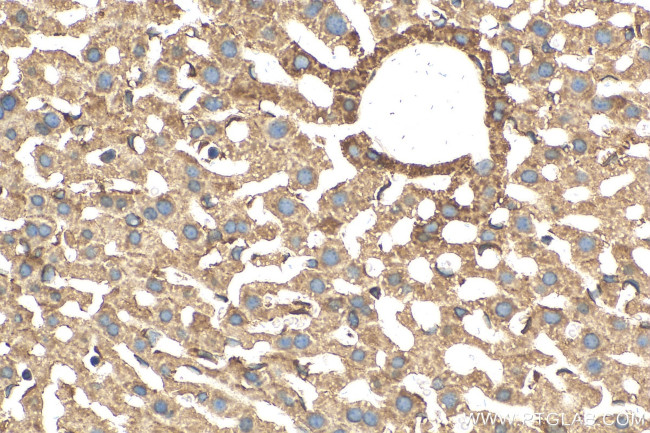
ABCC10 Antibody in Immunohistochemistry (Paraffin) (IHC (P))

Search
Proteintech
ABCC10 Polyclonal Antibody
{{$productOrderCtrl.translations['antibody.pdp.commerceCard.promotion.promotions']}}
{{$productOrderCtrl.translations['antibody.pdp.commerceCard.promotion.viewpromo']}}
{{$productOrderCtrl.translations['antibody.pdp.commerceCard.promotion.promocode']}}: {{promo.promoCode}} {{promo.promoTitle}} {{promo.promoDescription}}. {{$productOrderCtrl.translations['antibody.pdp.commerceCard.promotion.learnmore']}}
产品信息
30697-1-AP
种属反应
宿主/亚型
分类
类型
抗原
偶联物
形式
浓度
纯化类型
保存液
内含物
保存条件
运输条件
靶标信息
The MRP family is represented by nine similar ABC transporters that have the ability to transport structurally diverse lipophilic anions and operate as chemical efflux pumps. MRP7 (multidrug resistance-associated protein 7, ATPbinding cassette sub-family C member 10) is a multi-pass membrane protein that belongs to the ABC transporter family (conjugate transporter subfamily). MRP7 is involved with the ATP-dependent transport of 17β-estradiol-D-17-β-glucuronide (E217βG). MRP7 is also probably involved in cellular detoxification through its lipophilic anion extrusion capabilities. MRP7 contains two ABC transmembrane type 1 domains and two ABC transporter domains. MRP7 likely has three isoforms. Isoform 2 is the most widely expressed, while isoform 1 is predominately expressed in the spleen.
仅用于科研。不用于诊断过程。未经明确授权不得转售。
篇参考文献 (0)
生物信息学
蛋白别名: ATP-binding cassette sub-family C member 10; ATP-binding cassette, sub-family C (CFTR/MRP), member 10; Multidrug resistance-associated protein 7
基因别名: ABCC10; EST182763; mFLJ00002; MRP7; SIMRP7
UniProt ID: (Human) Q5T3U5, (Mouse) Q8R4P9
Entrez Gene ID: (Human) 89845, (Mouse) 224814